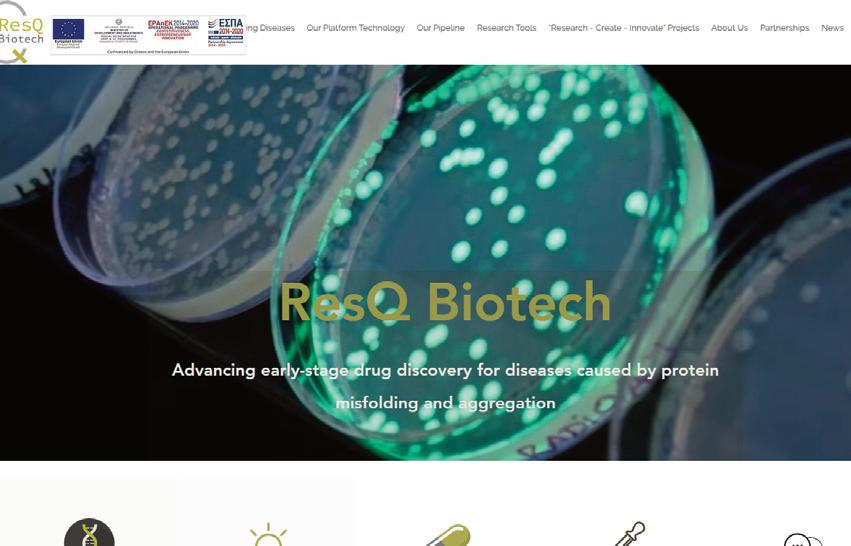

Ιδιοκτησία
mediahub
Τ:
email: startupper@startuppermag gr www
gr



Co-founder Estate Brains, Director Founder Institute, Greece

![]()






Ιδιοκτησία
mediahub
Τ:
email: startupper@startuppermag gr www
gr



Co-founder Estate Brains, Director Founder Institute, Greece





Newjobs.gr





1.
2. Axelera
3. Blueground: 40,25
4. Hellas Direct: 30
5. Numa: 28,98
6. Deepcure: 22 εκατ. ευρώ. Η DeepCure, co-founder της
7.
8. Plum:
9.


www.withplum.com


ISO/IEC 27001/2013
ISO/EIC 9001/2015
Metabio






Ο Madan Jagasia, CEO της Obsidian Therapeutics

Ο Rami Elghandour, Chairman
Chief Executive
Arcellx
Amgen και deCODE Genetics

www.mammoth.bio




Τι
www.illumina.com


10x Genomics (ΗΠΑ)


Ginkgo Bioworks (ΗΠΑ)
Τι
www.ginkgobioworks.com


Zymergen (ΗΠΑ) Τι


www.deepgenomics.com




www.tissuse.com


Mimetas (Ολλανδία)
www.mimetas.com

StemCell Technologies
www.stemcell.com

www.insilico.com




Τι
www.organovo.com


Τι
www.cellink.com

DenovoMATRIX (Γερμανία)
www.denovomatrix.com

www.whoop.com



www.dexcom.com

BioNTech (Γερμανία)



www.arcturusrx.com

www.perfectday.com


Geltor (ΗΠΑ)
www.geltor.com

Causaly www.causaly.com

Clue, Ida



Deloitte εκτιμά ότι η Femtech αγορά θα
ξεπεράσει τα 100 δισ. δολ. μέχρι το 2032, ενώ η McKinsey εκτιμά ότι θα φτάσει το 1 τρισ. δολ. ετησίως έως το 2040. Στις Ηνωμένες Πολιτείες, η αγορά Femtech αναμένεται να φτάσει τα 34,70 δισ. δολάρια μέχρι
Femtech Startups







ΟΙ
Maven Clinic
Η Maven
Oprah Winfrey, η Mindy Kaling και
Reese Witherspoon.
Flo Health
H
Kindbody




Elvie
H

Myovant Sciences


